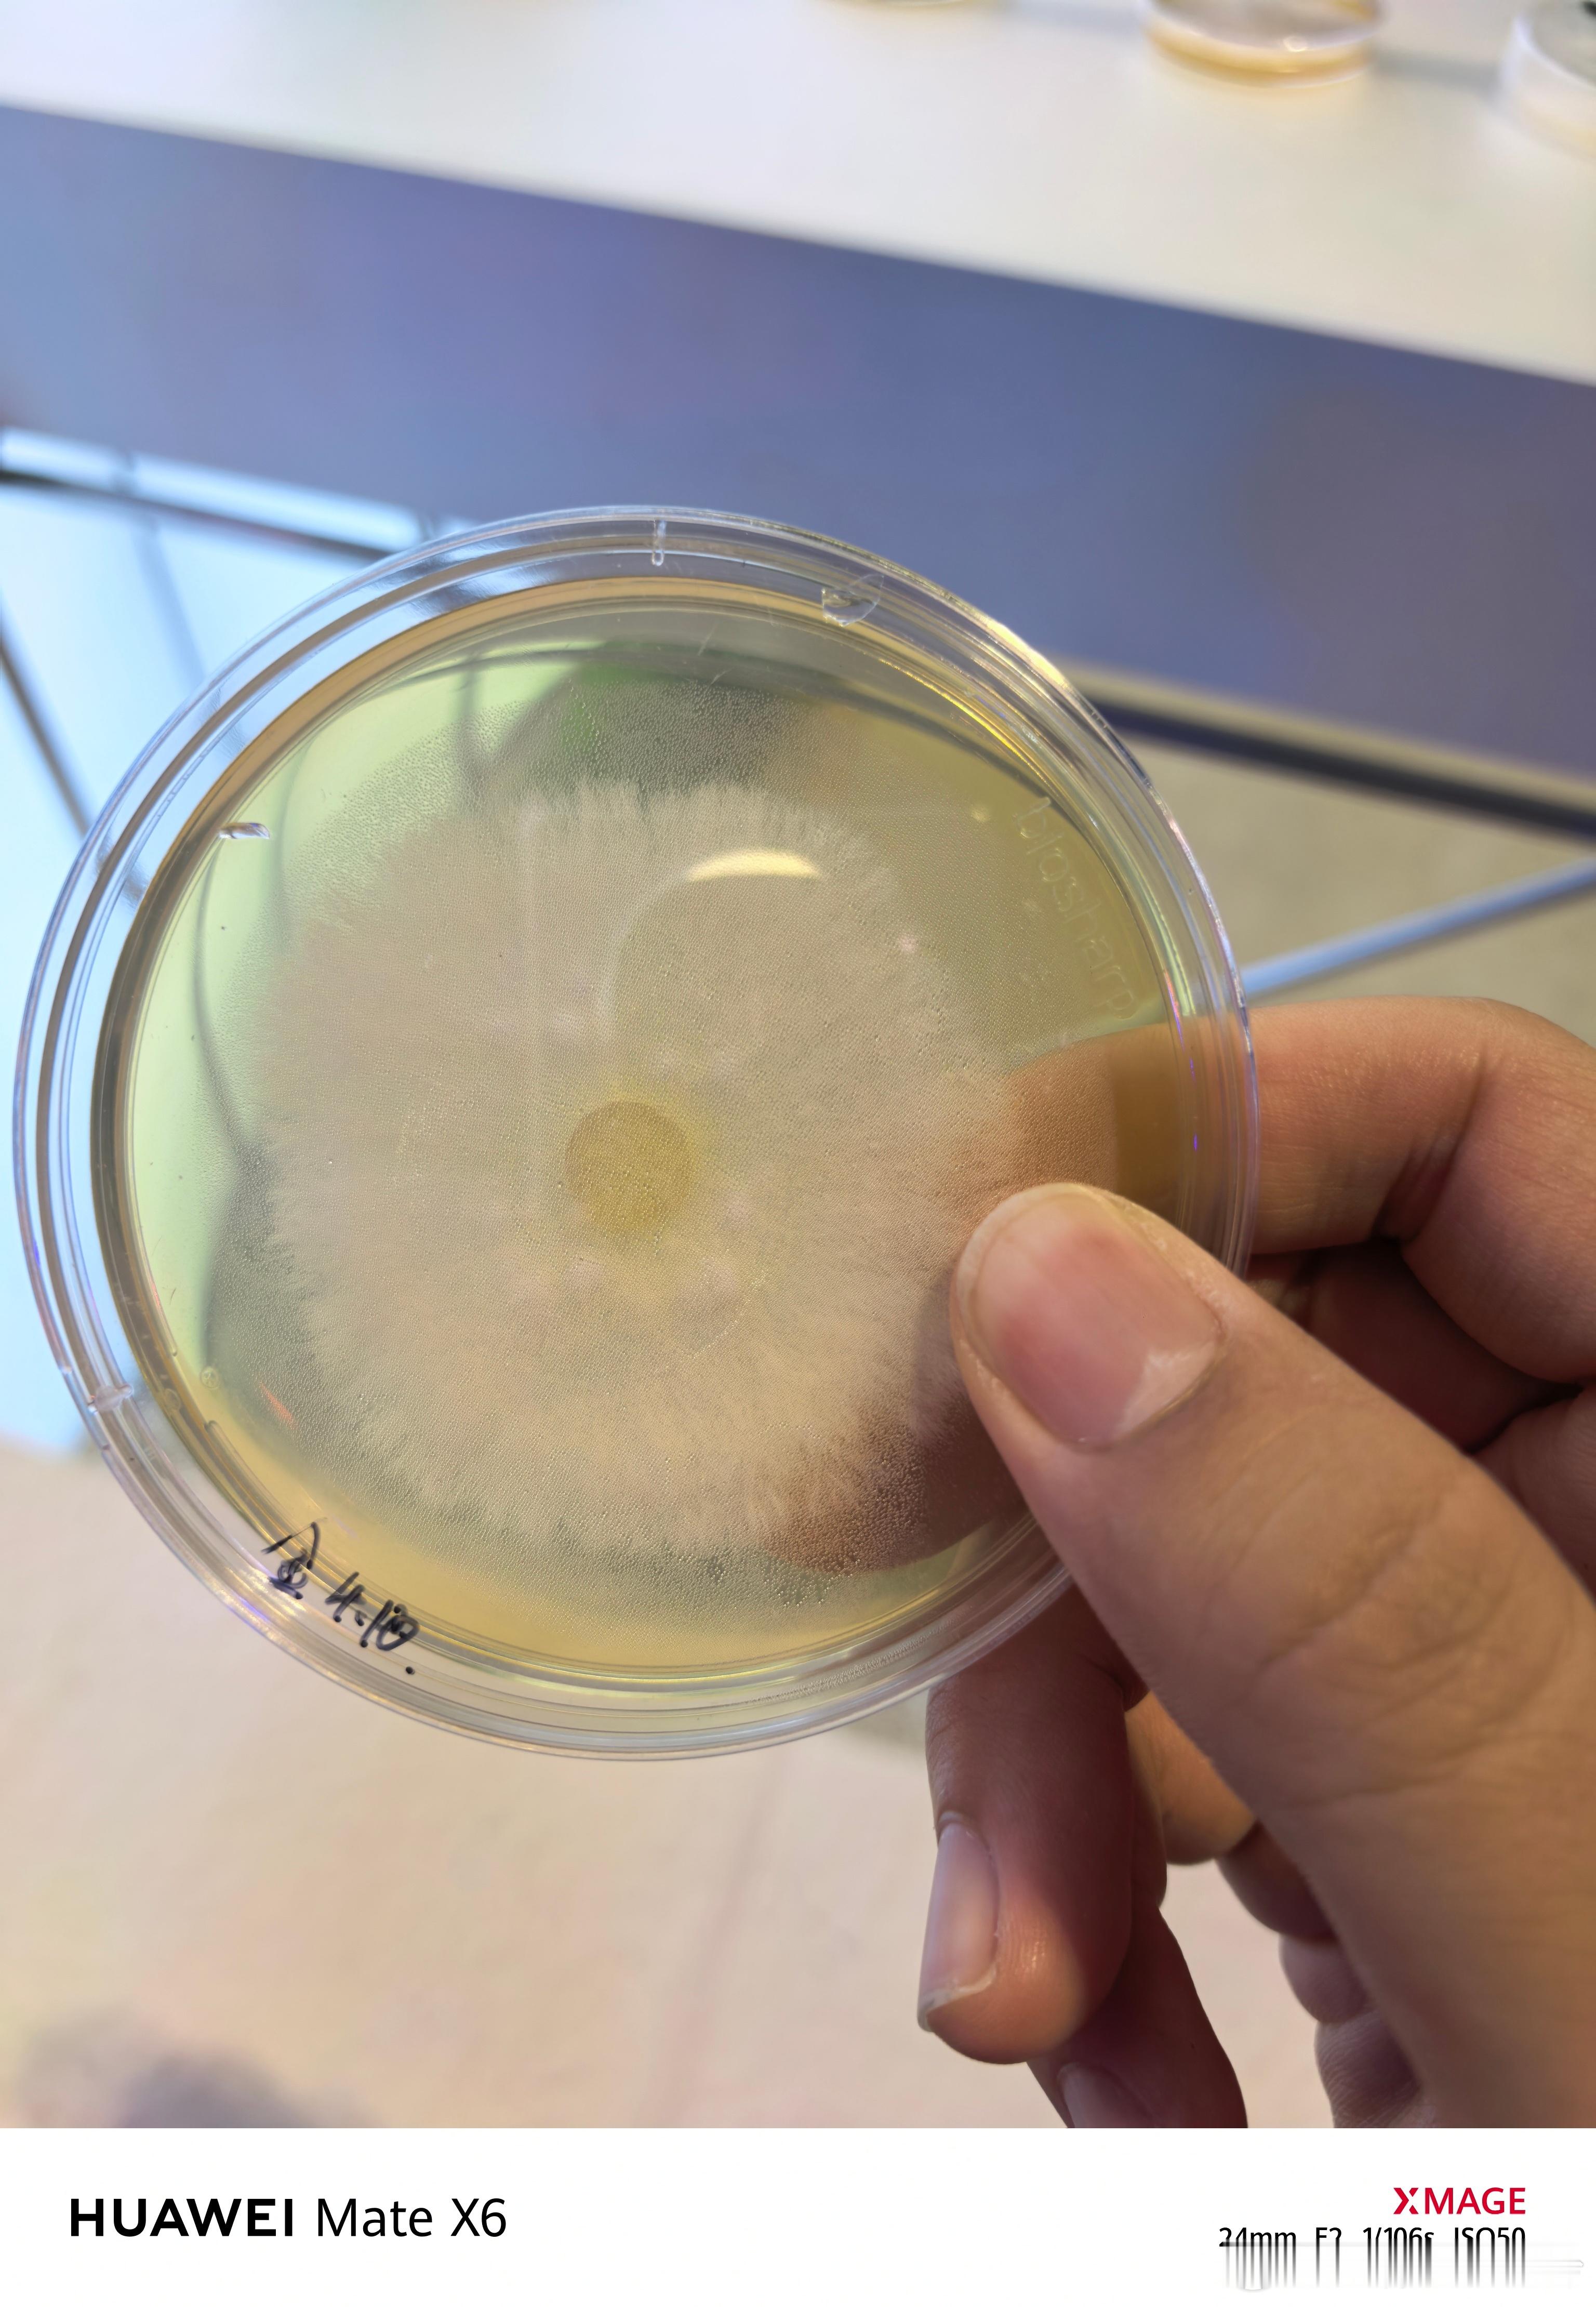

参加澳门BEYOND EXPO科技展[酷][酷]
FungiFuture这个展台大开眼界,用菌丝(蘑菇)做新的材料。比如:胶合板(菌丝代替胶、不释放甲醛)、动物皮(后续会用到LV包)…
成本低、可靠性高,关键是把它埋在地下,2-3年就能自然降解,不污染环境。
如果把它用在手机外壳代替素皮,那可真不能沾水了[喵喵][喵喵]










参加澳门BEYOND EXPO科技展[酷][酷]
FungiFuture这个展台大开眼界,用菌丝(蘑菇)做新的材料。比如:胶合板(菌丝代替胶、不释放甲醛)、动物皮(后续会用到LV包)…
成本低、可靠性高,关键是把它埋在地下,2-3年就能自然降解,不污染环境。
如果把它用在手机外壳代替素皮,那可真不能沾水了[喵喵][喵喵]

猜你喜欢
【1点赞】
【1评论】【1点赞】
【7评论】【4点赞】
作者最新文章
热门分类
科技TOP
科技最新文章